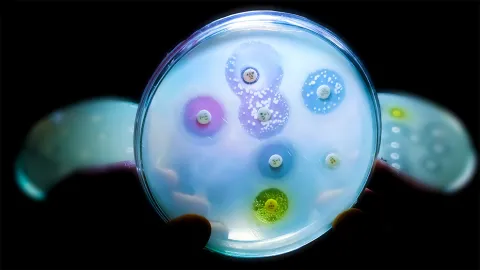

México.- Se calcula que para 2050 morirán 10 millones de personas cada año por infecciones resistentes a los antibióticos, alertó Samuel Ponce de León Rosales, coordinador del Programa Universitario de Investigación sobre Riesgos Epidemiológicos y Emergentes (PUIREE) de la UNAM.
Desde que Alexander Fleming descubrió la penicilina en 1928 y el primer paciente la recibió en 1941, el uso de antibióticos ha sido creciente en todo el mundo, pero muchas veces también inadecuado e indiscriminado, sostuvo.
Este abuso ha traído como consecuencia la resistencia antimicrobiana, que aumenta conforme hay mayor consumo. “Es un riesgo constante para la salud pública, un problema para la práctica médica y un desastre económico”.
Ponce de León afirmó que los antibióticos representan seguridad al prevenir y curar procesos infecciosos en humanos y animales, pero su utilización inadecuada nos perjudica a todos y tiene consecuencias sociales y económicas graves.
Al ofrecer una conferencia sobre el tema en la sesión cinco de la Cátedra Extraordinaria de Bioética, organizada por el Programa Universitario de Bioética (PUB) de la UNAM, el médico epidemiólogo subrayó que hay una sola acción central para evitar que la resistencia antimicrobiana siga creciendo: reducir el empleo de antibióticos.
Ante la moderadora Carol Hernández Rodríguez, investigadora del PUB, el experto dijo que “la resistencia es resultado natural de la interacción microbiana, que se potencializa al entrar en una espiral que involucra la utilización industrial de los antibióticos, su persistencia en el ambiente, su expansión geográfica, el uso clínico intensivo y la modificación de la microbiota intestinal, y todo esto resulta en una infección resistente a los antibióticos y en su diseminación. Pero la resistencia no es un fenómeno moderno, ha existido naturalmente desde hace miles de años”.
Las vías por las que las bacterias se hacen resistentes a estos medicamentos son múltiples: producen enzimas que destruyen a los antibióticos, ocurren mutaciones que modifican los sitios a donde estos se van a fijar, expulsan activamente al antibiótico de su interior por un sistema de bombeo o lo evitan alterando la permeabilidad a estas moléculas.
Futuro
Ponce de León destacó que los antibióticos son un recurso no renovable y su empleo inadecuado nos perjudica a todos, porque tienen una importancia social extraordinariamente grande.
Resaltó que cuando no tengamos antibióticos útiles, las cirugías serán mucho más complejas, con más riesgo; los trasplantes se limitarán de acuerdo con la disponibilidad de ese fármaco; las heridas simples serán de alto riesgo.
Con el uso inadecuado e indiscriminado de antibióticos, alertó, la mortalidad aumentará, los costos de los tratamientos antiinfecciosos crecerán y múltiples procedimientos no serán factibles o representarán un gran riesgo.
Hoy en día, agregó, nadie lo considera así, pero la mortalidad en diabetes, insuficiencia renal,infecciones dentales y otras será muy alta. “Se calcula que para 2050, dentro de 25 años, fallecerán 10 millones de personas cada año por infecciones resistentes a los antibióticos”, alertó.
El empleo de antibióticos, hasta el momento, ha influido mucho en la mortalidad. Por ejemplo, antes de que existieran dichos medicamentos la mortalidad por neumonía era del 35 % y actualmente es de menos del 10 %; mientras que por infecciones cardiacas antes morían cien por ciento de los pacientes y hoy menos del 25 %.
“La Organización de las Naciones Unidas, el 21 de septiembre de 2016, hizo una declaratoria de emergencia global y llevó el asunto de la resistencia antimicrobiana a la atención del Consejo de Seguridad de Naciones Unidas. La Organización Mundial de la Salud también lo denominó así e incluso instituciones que tienen poco que ver con este tipo de asuntos, como el Banco Mundial y el Foro Económico Mundial en Davos, lo calificaron como un problema muy grave con una inmensa repercusión económica”, recordó.
Ponce de León consideró que se trata también de un asunto bioético relacionado con la beneficencia, la no maleficencia y la justicia, en consideración de un bien mayor. “Si los antibióticos son un bien público y un recurso no renovable, su uso debería restringirse y ser muy bien reflexionado por quienes los están prescribiendo. La distribución de la riqueza determina el acceso a ellos, pero la resistencia se distribuye globalmente, no sólo donde se están empleando directamente”, finalizó.
¿Quieres mantenerte a tanto de todas las noticias hoy en Puebla? ¡Explora más en nuestro portal ahora mismo!
Foto Especial
mala